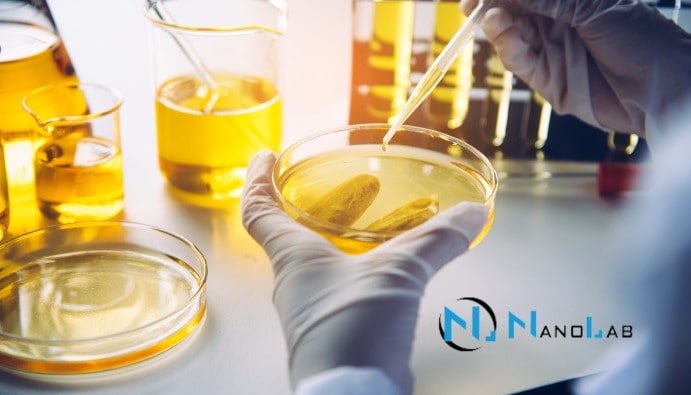

식품의 수단 염료 분석 더 읽어보기

BLOG

식품의 수단 염료 분석 더 읽어보기

광유의 총 염기 번호(TBN) 분석 더 읽어보기

광유의 총 오일 수(TAN) 분석 더 읽어보기
광유분석실 더 읽어보기

광유 분석 및 그 중요성 더 읽어보기

미네랄 오일 분석 더 읽어보기